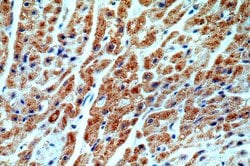
ST8SIA2 Rabbit anti-Human, Mouse, Rat, Polyclonal, Proteintech 150 &mu;L;

missing translation for 'onlineSavingsMsg'
Learn More
Learn More
ST8SIA2 Rabbit anti-Human, Mouse, Rat, Polyclonal, Proteintech
Rabbit Polyclonal Antibody
Brand: Proteintech 19736-1-AP-150UL
This item is not returnable.
View return policy
Description
The antibody is specific to ST8SIA2.
The protein encoded by this gene is a type II membrane protein that is thought to catalyze the transfer of sialic acid from CMP-sialic acid to N-linked oligosaccharides and glycoproteins. The encoded protein may be found in the Golgi apparatus and may be involved in the production of polysialic acid, a modulator of the adhesive properties of neural cell adhesion molecule (NCAM1). This protein is a member of glycosyltransferase family 29.Specifications
| ST8SIA2 | |
| Polyclonal | |
| Unconjugated | |
| ST8SIA2 | |
| Alpha 2,8 sialyltransferase 8B, HsT19690, Sialyltransferase 8B, Sialyltransferase X, Sialytransferase St8Sia II, SIAT8 B, SIAT8B, ST8SIA II, ST8SIA2, ST8SiaII, STX | |
| Rabbit | |
| Antigen Affinity Chromatography | |
| RUO | |
| 117523, 20450, 8128 | |
| -20°C | |
| Liquid |
| Immunohistochemistry (Paraffin), Western Blot | |
| 0.13 mg/mL | |
| PBS with 50% glycerol and 0.02% sodium azide; pH 7.3 | |
| O35696, Q07977, Q92186 | |
| ST8SIA2 | |
| Peptide | |
| 150 μL | |
| Primary | |
| Human, Mouse, Rat | |
| Antibody | |
| IgG |
Product Content Correction
Your input is important to us. Please complete this form to provide feedback related to the content on this product.
Product Title
Spot an opportunity for improvement?Share a Content Correction